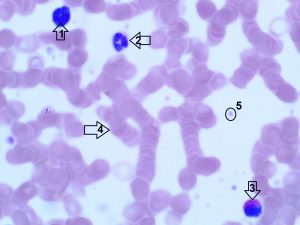

O sangue é um fluido viscoso, levemente alcalino (pH, 7,4), cuja cor varia de vermelho brilhante a vermelho-escuro e que corresponde a aproximadamente 7% do peso do corpo. O volume total do sangue de um adulto médio é de cerca de 5 L, e ele circula por todo o corpo, dentro dos limites do sistema circulatório.
O sangue é um tipo especial de tecido conjuntivo que pode ser dividido em duas partes: plasma (parte liquida) e células sanguineas (elementos figurados do sangue).
Os glóbulos sanguíneos são os eritrócitos ou hemácias ou glóbulos vermelhos, as plaquetas e diversos tipos de leucócitos ou glóbulos brancos.
Funções do sangue
O sangue é principalmente um meio de transporte. Por seu intermédio, os leucócitos, dos quais alguns são fagocitários e representam uma das primeiras barreiras contra infecção, percorrem todo o corpo e podem concentrar-se nos tecidos atingidos por infecção, atravessando a parede dos capilares. O sangue transporta oxigênio e gás carbônico, o primeiro ligado à hemoglobina dos eritrócitos e o segundo ou ligado à hemoglobina ou dissolvido no plasma sob a forma de bicarbonato. Transporta escórias do metabolismo, que são removidas do sangue pelos órgãos de excreção. Tem ainda papel regulador na distribuição de calor, do equilíbrio acidobásico e do equilíbrio osmótico. Serve também como veículo de distribuição dos hormônios, o sangue possibilita a troca de mensagens químicas entre órgãos distantes.
O Hematócrito
O hematócrito é uma medida da proporção de hemácias no sangue. O valor é expresso como um percentagem ou uma fração de hemácias no sangue. Por exemplo, um hematócrito de 40% significa que há 40 ml de hemácias em 100 ml de sangue. O hematócrito se eleva quando o número de hemácias aumenta ou quando o volume de plasma diminui, como na desidratação. O hematócrito diminui até menos que o normal, indicando anemia, quando reduz a produção
Quando sangue é retirado do corpo e colocado em um tubo de ensaio, ele coagula, exceto quando a luz do tubo tenha sido revestida com um anticoagulante, como a heparina. O sangue com anticoagulante (heparina), centrifugado, sedimenta-se em várias camadas. A camada inferior, mais densa (celular) são as hemácias, e constituem cerca de 45% do volume sanguíneo. Esta percentagem do volume dos eritrócitos é o hematócrito. A camada imediatamente superior é chamada papa leucocitária e representa a camada de sedimentação dos leucócitos. Sobre os leucócitos repousa uma delgada camada de plaquetas, não visíveis a olho nu. A fração sobrenadante transparente acima das hemácias sedimentadas é o plasma. Embora o hematócrito seja toda a parte celular do sangue não-coagulado, no ponto de vista prático, pode-se caracterizar o hematócrito como a quantidade de hemácias presente no sangue.
O soro e o plasma
Vários exames no laboratório clínico, por exemplo os de bioquímica e sorologia, são realizados utilizando o soro. Muitos podem ser feitos utilizando o plasma mas, pela praticidade e qualidade (líquido livre de células), a maioria dos laboratórios utilizam o soro.
O soro é obtido após a coleta, coagulação da amostra e posterior centrifugação, sendo que nenhum anticoagulante é utilizado. O objetivo é que haja a formação de coágulo, e nesse processo os fatores da coagulação, plaquetas e fibrinogênio são consumidos.
Então, de forma simplificada, o soro é a parte líquida do sangue sem o fibrinogênio e fatores da coagulação enquanto o plasma é a parte líquida do sangue com o fibrinogênio e fatores da coagulação.
No laboratório, é possível obter o plasma da amostra através da adição de um anticoagulante no tubo de coleta. Existem vários tipos de anticoagulantes, como por exemplo o EDTA, o citrato de sódio, a heparina etc.
Composição do plasma
O plasma é uma solução aquosa contendo componentes de pequeno e elevado peso molecular, que correspondem a 10% do seu volume. As proteínas plasmáticas correspondem a 7%, e os sais inorgânicos, a 0,9%, sendo o restante formado por compostos orgânicos diversos, tais como aminoácidos, vitaminas, hormônios e glicose.
O plasma é um veículo para o transporte de moléculas diversas. Entre as proteínas do plasma podem ser citados a albumina, as alfa, beta e gamaglobulinas e o fibrinogênio. A albumina representa um papel fundamental na manutenção da pressão osmótica do sangue. As gamaglobulinas são anticorpos, são chamadas de imunoglobulinas. O fibrinogênio é necessário para a formação de fibrina, na etapa final da coagulação do sangue. Diversas substâncias, que são insolúveis ou pouco solúveis em água, podem ser transportadas pelo plasma devido ao fato de se combinarem com a albumina ou com as α e β-globulinas, as quais atuam como transportadoras.
Coloração das células do sangue
O exame ao microscópio óptico das células do sangue circulante é realizado fazendo um esfregaço de uma gota de sangue sobre uma lâmina histológica, secando esta preparação ao ar e corando-a com misturas de corantes destinadas especificamente para demonstrar características típicas destas células. Os métodos atuais derivam da técnica criada no fim do século XIX por Romanovsky, que usou uma mistura de azul de metileno e eosina. Hoje em dia, a maioria dos laboratórios usa as modificações de Wright ou de Giemsa do procedimento original, e a identificação das células do sangue baseia-se nas cores produzidas por estes corantes. O azul de metileno cora componentes celulares ácidos em azul (basófilos), e a eosina cora os componentes alcalinos (acidófilos) em rosa.
Os componentes celulares do sangue
Os glóbulos vermelhos, ou hemácias ou eritrócitos
Os eritrócitos são células anucleadas em forma de disco bicôncavo. Apresentam uma coloração rósea-clara, quando corados pela hematoxilina-Eosina, com um halo central mais claro em conseqüência da biconcavidade. Este halo central nos eritrócitos normais corresponde a 1/3 do diâmetro da célula. Durante sua maturação na medula óssea, o eritrócito perde o núcleo e as outras organelas, não tendo, portanto, a possibilidade de renovar os sistemas enzimáticos, proteínas estruturais, lipídios e polissacarídeos, essências para a vida do corpúsculo, possuindo um tempo de vida limitado de cerca de 120 dias. Após esse período, sua membrana torna-se mais rígida, sendo incorporada pelo sistema retículo-endotelial, baço, fígado, e tendo seus componentes reaproveitados, inclusive o componente proteico da membrana, como a hemoglobina, para a formação de novas hemácias. A quantidade de hemácias presente no sangue de um indivíduo normal é na ordem de 3 a 4 milhões por decilitro de sangue. Se for analisada a quantidade de leucócitos (células brancas), outro grupo células presente, é observada uma quantidade muito inferior, sendo de 5 mil a 8 mil leucócitos por decilitro de sangue. Por isso, considera-se, na prática, que quase todo o hematócrito é constituído de células vermelhas.
O diâmetro dos eritrócitos varia de 6 μm a 8,5 μm. A função dos eritrócitos é o transporte de O2 e CO2.

Leucócitos
Os leucócitos são células que participam das defesas celulares e imunocelulares do organismo. Constantemente os leucócitos deixam os capilares por diapedese e migram para o local da inflamação. São produzidos na medula óssea vermelha, permanecendo temporariamente no sangue. Possuem 2 classificações, os granulócitos e os agranulócitos.
Os granulócitos, também conhecidos por polimorfonucleares, são assim chamados por apresentarem granulações específicas no citoplasma e núcleo multilobulados, dispondo seu núcleo de forma irregular. Eles distinguem-se em três tipos de granulócitos: neutrófilos, eosinófilos e basófilos.
Os agranulócitos, dispõem seu núcleo sem lobulações, possuindo uma forma mais regular, e seu citoplasma não apresenta granulações especificas sendo chamados de mononucleares. Há dois tipos de agranulócitos: os linfócitos e os monócitos.
O número normal de leucócitos no adulto é de 4.500 a 11.500 por microlitro (mm3) de sangue. O aumento no número de leucócitos o sangue chama-se leucocitose e a diminuição leucopenia. A contagem do número de leucócitos circulantes, feita pelo hemograma, pode apontar para a existência de diversos tipos de infecções; do mesmo modo, a análise morfológica do núcleo e do citoplasma dos leucócitos pode ser decisivo para o diagnóstico de diferentes doenças e síndromes.
Neutrófilos
Os neutrófilos são os leucócitos mais presentes no sangue, representando cerca de 60 a 65% dos leucócitos do sangue circulante normal.
Os neutrófilos contêm grânulos específicos muito pequenos e grânulos azurófilos. Os grânulos azurófilos contêm fosfatase ácida e outras enzimas lisosômicas. Os grânulos específicos contêm enzimas que matam as bactérias fagocitadas.
São células arredondadas, e apresenta seus núcleos formados por 2 a 5 lóbulos, ligados entre si por finas pontes de cromatina. Dependendo da quantidade de lóbulos nucleares, os neutrófilos dividem-se em bi, tri, tetra e pentalobulado. Com mais de 5 lóbulos são chamadas ‘hipersegmentadas’, sendo essas células muito velhas. A célula muito jovem não apresenta seu núcleo em lóbulos, e sim em um segmento, sendo então chamado de neutrófilo bastonete.
Eles estão relacionados a infecções do tipo bacteriana. Constituem a primeira linha de defesa celular contra a invasão de microorganismos, sendo fagócitos ativos de partículas de pequenas dimensões.
Os núcleos dos neutrófilos das pessoas do sexo feminino, mostram-se constantemente um pequeno apêndice, muito menor do que um lóbulo nuclear, com a forma de uma raquete. Essa raquete contém a cromatina sexual, constituída por um cromossomo X heterocromático (condensado) que não transcreve seus genes.
O neutrófilo é uma célula que se apresenta em seu estágio final de diferenciação, realizando uma síntese proteica muito restrita. Mostra poucos perfis do retículo endoplasmático granuloso, raros ribossomos livres, poucas mitocôndrias e complexo de Golgi rudimentar.

Eosinófilos
Os eosinófilos representam cerca de 2-4% dos leucócitos. Essas células tem aproximadamente o mesmo tamanho dos neutrófilos. O núcleo é segmentado apresentando geralmente 2 lóbulos (bilobulado). Apresentam granulações azurófilas e específicas acidófilas que se coram pela eosina. Os grânulos específicos contém a proteína básica principal, a proteína catiônica do eosinófilo e a neurotoxina derivada dos eosinófilos, as duas primeiras das quais são agentes altamente eficientes no combate aos parasitos. Os grânulos azurófílos inespecíficos são lisossomos contendo enzimas hidrolíticas semelhantes às encontradas nos neutrófilos. Estas funcionam na destruição de vermes parasitários e na hidrólise de complexos antígeno-anticorpos internalizados pelos eosinófilos. Em algumas parasitoses e nas doenças alérgicas o número de eosinófilos aumenta. No eosinófilo o retículo endoplasmático, as mitocôndrias e o aparelho de Golgi são pouco desenvolvidos.
Basófilos
Os basófilos são os leucócitos circulantes mais raros, correspondem menos de 1% dos leucócitos. Apresentam núcleo volumoso, geralmente com aspecto de letra S. O citoplasma é carregado de grânulos maiores do que os outros granulócitos contendo histamina, heparina, fatores quimiotáticos para eosinófilos e neutrófilos. Essas granulações quando coradas pelos corantes panóticos apresentam-se de cor violeta. Seus grânulos são metacromáticos. Participam dos processos alérgicos e possuem receptores para imunoglobulinas E. Eles liberam seus grânulos e as substâncias ativas neles contidas para o meio extracelular, sob a ação dos mesmos estímulos que promovem a expulsão dos grânulos dos mastócitos. Os basófilos e os mastócitos são células diferentes, pois apresentam diferenças em sua origem e morfologia. Os basófilos têm um papel na hipersensibilidade imediata (asma brônquica) e tardia (reação alérgica cutânea) e na propagação da resposta imunológica.

Linfócitos
Os linfócitos são responsáveis pela defesa imunológica do organismo. Essas células reconhecem moléculas estranhas existentes em diferentes agentes infecciosos. Combatendo por meio de resposta humoral (produção de imunoglobulinas) e resposta citotóxica mediada por células. Eles representam de 20 a 30% dos leucócitos na circulação. Podendo ser encontrados nos mais variados tamanhos, com diâmetro variável entre 6 e 8 μ.m, conhecidos como linfócitos pequenos; e uma pequena porcentagem de linfócitos maiores, que podem alcançar 18 μm de diâmetro.
Apresentam núcleo arredondado e excêntrico com cromatina densa. Seu citoplasma é muito escasso com basofilia discreta e granulações azurófilas.
Os linfócitos podem ser divididos em 2 tipos, T e B. A célula precursora dos linfócitos se origina na medula óssea. Os linfócitos B estão envolvidos na defesa humoral do organismo, pois se diferenciam-se em plasmócitos, que por sua vez, produzem os anticorpos. Os linfócitos T são os mais numerosos no sangue. Estes são fundamentais pelas respostas imunitárias de base celular, que não dependem dos anticorpos circulantes. A função dos linfócitos T é facilitar a produção de anticorpos pelos linfócitos B. Graças a estas células, quando um antígeno invade o organismo pela segunda vez, a resposta imunitária em geral é muito mais intensa e mais rápida.
Apesar de, morfologicamente, eles serem indistinguíveis uns dos outros, eles podem ser reconhecidos imunocitoquimicamente pelas diferenças em seus marcadores de superfície. Aproximadamente 80% dos linfócitos circulantes são células T, e o restante são células B.

Monócitos
Os monócitos são os maiores leucócitos circulantes, e representam de 4 a 8% dos leucócitos na circulação sanguínea, possuem diâmetro entre 15 e 22 μm. O núcleo é grande ovóide, em forma de rim ou ferradura. Devido ao arranjo pouco denso de sua cromatina, o núcleo dos monócitos é mais claro do que o dos linfócitos, possuindo de dois ou três nucléolos, que algumas vezes podem ser vistos nos esfregaços comuns.
O citoplasma dos monócitos possuem uma pequena quantidade de polirribossomos e retículo endoplasmático granuloso (pouco desenvolvido). Encontram-se muitas mitocôndrias pequenas, e complexo de Golgi grande, participando da formação dos grânulos azurófilos. A superfície celular mostra muitas microvilosidades e vesículas de pinocitose.
Os monócitos do sangue representam uma fase na maturação da célula mononuclear fagocitária originada na medula óssea. Esta célula passa para o sangue, onde permanece apenas por alguns dias, e, atravessando por diapedese a parede dos capilares e vênulas, penetra alguns órgãos, transformando-se em macrófagos, que constituem uma fase mais avançada na vida da célula, fazendo parte do sistema fagocítário mononuclear.

Plaquetas
As plaquetas são corpúsculos anucleados e apresentam forma irregular. São fragmentos do citoplasma de células gigantes poliploides localizadas na medula óssea chamadas megacariócitos. Possuem forma discoide com diâmetro variável entre 2 e 4μm e são responsáveis pela coagulação sanguínea e auxiliam na reparação da parede dos vasos sanguíneos. Sua vida média é de nove dias. O número de plaqueta no sangue periférico varia de 150.000 a 400.000 plaquetas/μL de sangue. Em preparações de esfregaço sanguíneo, as plaquetas usualmente aparecem aglutinadas e apresentam coloração azul-clara.
As plaquetas possuem um sistema de canais chamado sistema canalicular aberto, que se comunica com invaginações da membrana plasmática, permitindo que o seu interior se comunique facilmente com a sua superfície. Essa comunicação é importante, pois garante a liberação de moléculas armazenadas nas plaquetas. O citoplasma é divido em duas regiões: 1) o hialômero, região mais clara localizada na periferia rica em filamentos de actina e miosina, responsáveis pela contração da plaqueta e pela emissão de finos prolongamentos chamadas de filopódios; 2) o granulômetro, região mais central que apresenta grânulos delimitados por membrana contendo ADP, ATP, serotonina, fibrinogênio, histamina, cálcio e alguns fatores de crescimento.








Referências:
JUNQUEIRA, Luiz Carlos Uchoa. Histologia básica I L.C.Junqueira e José Carneiro.12 .ed. Rio de Janeiro: Guanabara Koogan, 2013.